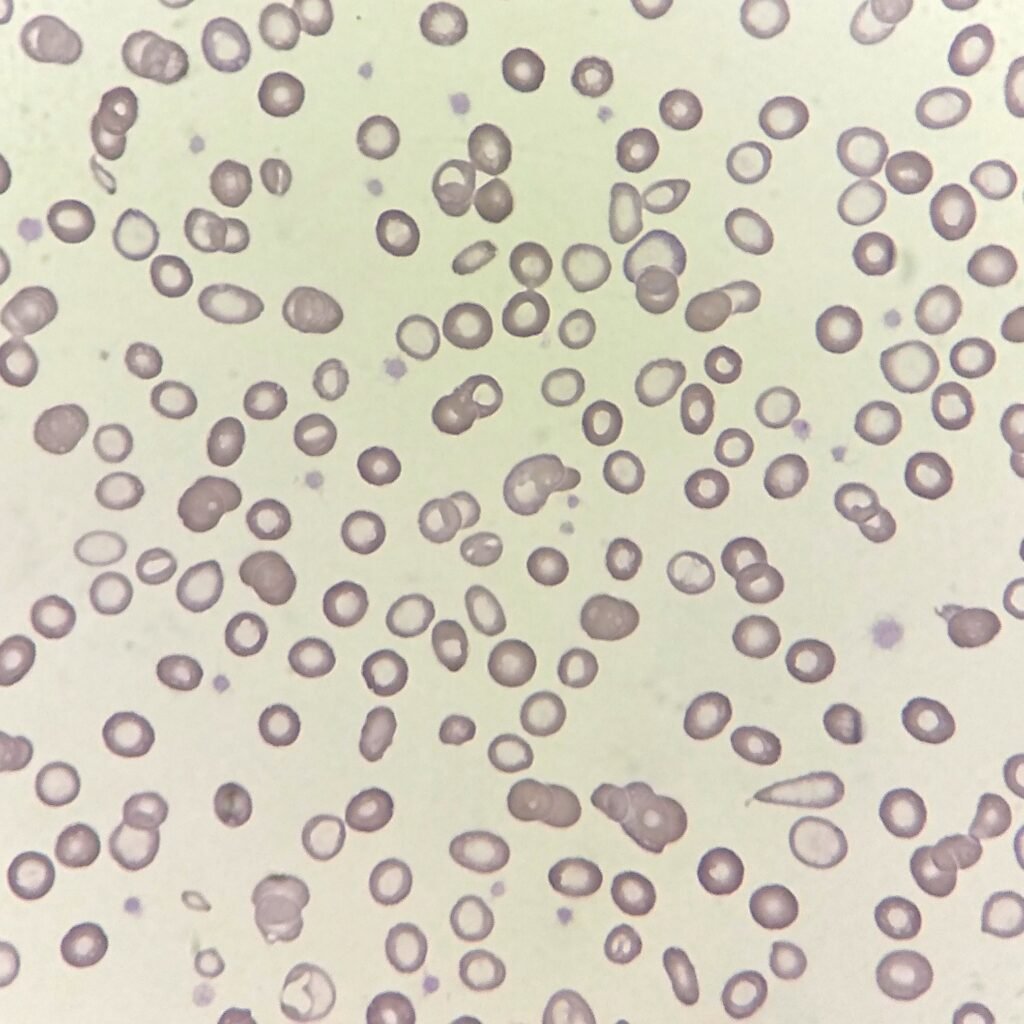
RBC Morphology based on Indices, Low MCHC, Hypochromasia, Increased Central Pallor

Anemia of Chronic Inflammation, also known as Anemia of Chronic Disease, is exactly as its name suggests: anemia due to chronic inflammatory conditions. Such conditions may include cancer, autoimmune diseases, infections, and chronic kidney disease. The anemia is usually treated by treating the underlying condition.
Pathophysiology
Acute phase reactants are proteins that are significantly increased or decreased in response to inflammation. Among the proteins that are increased are ferritin and hepcidin.
Increased ferritin levels cause more iron to be kept in stores instead of being used for erythrocyte production.
Hepcidin regulates iron levels by decreasing intestinal absorption of iron and causing macrophages to retain iron recovered from recycled red blood cells.
The purpose of this iron sequestration is to limit its availability to harmful pathogens. This is known as “nutritional immunity.” With chronic inflammation, however, the increased ferritin and hepcidin lead to a decrease in the amount of available iron for erythrocyte production over time despite there being sufficient stores.
Further compounding the issue are inflammatory cytokines which inhibit the production of erythropoietin and increase the erythrophagocytotic activity of macrophages.
Laboratory Findings
The peripheral blood smear typically shows a hypochromic, microcytic anemia. Ferritin levels are increased, as it is an acute phase reactant. Through the mechanisms explained under pathophysiology, increased ferritin and hepcidin lead to decreased iron. It is important to note, however, that iron deficiency anemia may be present in conjunction with anemia of chronic inflammation.
In the bone marrow, the myeloid:erythroid ratio is increased. This is because erythrocyte production is reduced and the underlying condition typically leads to increased myeloid production.
References
- 4.2: Anemia of Chronic Inflammation/Disease (ACI/ACD) – Medicine LibreText
- Anemia of Inflammation or Chronic Disease – NIDDK
- Anemia of Chronic Disease: Symptoms, Treatment & Causes
- Anemia of inflammation | Blood | American Society of Hematology
- Anemia of Chronic Disease – Anemia of Inflammation | Choose the Right Test
- Anemia of Chronic Disease – Blood Disorders – Merck Manual Consumer Version
- Physiology, Acute Phase Reactants – PubMed
- Physiology, Hepcidin – StatPearls – NCBI Bookshelf
- Effect of Inflammatory Cytokines on Hypoxia-Induced Erythropoietin Production – ScienceDirect
